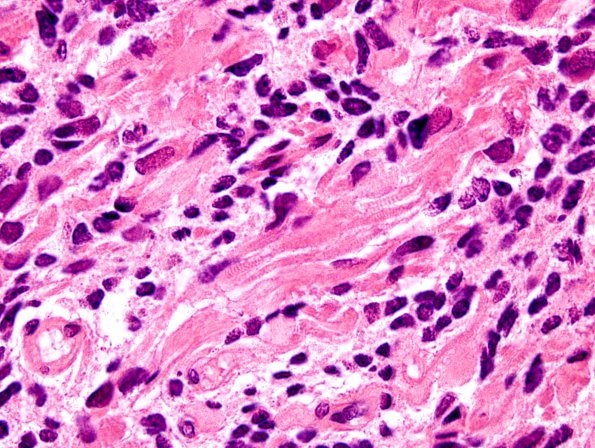
4A11 Medullomyoblastoma (Case 4) H&E 14A

Table of Contents
Washington University Experience | NEOPLASMS (EMBRYONAL) | Medulloblastoma, Histologically Defined | Medullomyoblastoma | 4A11 Medullomyoblastoma (Case 4) H&E 14A
These are characterized by the presence of many large, elongated cells with abundant eosinophilic cytoplasm and nuclei with a prominent nucleolus.